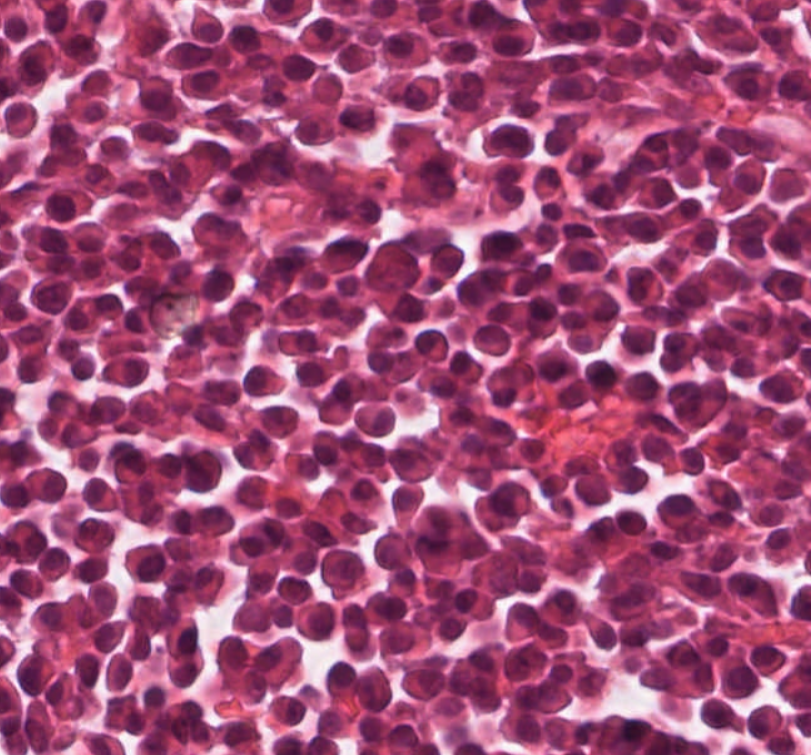
What neoplasm is causing this clavicular mass in a 65 year old man? View the whole slide on the Leeds Virtual Pathology Website here 🔬🔬🔬virtualpathology.leeds.ac.uk/slides/library… #softtissuepath #pathX #caseoftheweek

Virtual Pathology at The University of Leeds
@leedspathology
The Virtual Pathology project at the University of Leeds. Any use of website material.. please credit by citation of source. Commercial use by permission only.
ID: 273933225
http://www.virtualpathology.leeds.ac.uk 29-03-2011 12:10:04
1,1K Tweet
8,8K Followers
691 Following


A reminder that registration is open for the final webinar in this series of free educational webinars all on digital pathology topics. This will be taking place on Tuesday 11th March 2025 from 3pm to 4pm. Please register here: events.teams.microsoft.com/event/b46d9cac… #digitalpathology




Remember to register and join us next Tuesday, 11th March. We'll be joined by senior members of NPIC to discuss key opportunities, challenges and achievements of the National Pathology Imaging Co-Operative. Followed by a live Q&A. Register here: events.teams.microsoft.com/event/b46d9cac…

Reminder to register for the final webinar in this series of free educational webinars on digital pathology! It will be taking place tomorrow from 3-4pm GMT. Registration is still open, don't miss out! Follow this link for registration information: events.teams.microsoft.com/event/b46d9cac…